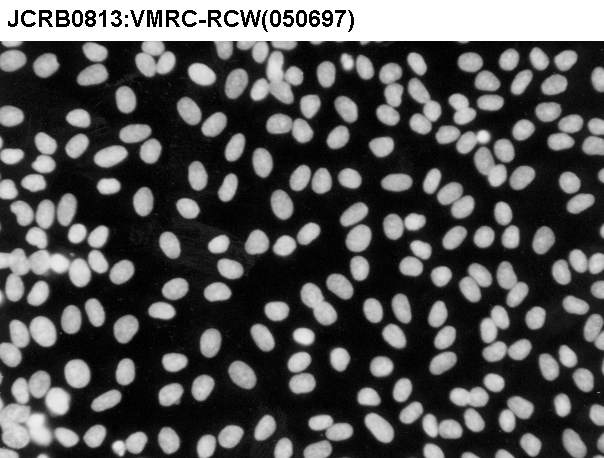

JCRB0813 VMRC-RCW
細胞情報
細胞種類:一般細胞 (細胞分譲手数料はこちら)
| 細胞番号(JCRB) | JCRB0813 | 細胞名 | VMRC-RCW |
|---|---|---|---|
| 生物種(日本語) | ヒト | 組織名(日本語) | 腎臓 |
| コメント(日本語) | 腎細胞がん | プロフィール | renal cell carcinoma |
| 別名 | Thomas Wirts | 動物名 | human |
| 系統名 | 学名・属名 | Homo | |
| 学名・種小名 | sapiens | 性別 | M |
| 年齢・月齢 | 細胞識別情報 | available | |
| (癌)原発組織名 | kidney | 病歴情報 | |
| 転移の有無(Y/N) | (癌)転移組織名 | ||
| 遺伝的性質 | renal cell carcinoma | 細胞寿命 | infinite |
| クライシスPDL | 形態 | ||
| 一般性状 | renal cell carcinoma | 細胞分類 | |
| 細胞樹立者名 | Akiyama,M. | 細胞寄託者 | Akiyama,M. |
| 分譲時制限 | コメント | ||
| 入手年 | 1987 | 培養培地 | Eagle's minimal essential medium with 10% fetal calf serum |
| 継代方法 | 0.25% trypsin and dilute in fresh medium. Change medium twice a week | 継代時細胞数 | split ratio=1/6 |
| 人種 | 炭酸ガス濃度 | 5 % | |
| 採取組織名 | renal | 組織型 |
| ウイルスDNA・RNA検出検査 (Detection of virus genome fragment by Real-time PCR) | |||||||||
|---|---|---|---|---|---|---|---|---|---|
| ウイルスDNA 検出検査 |
tested | ウイルスRNA 検出検査 |
tested | ||||||
| CMV | - | parvoB19 | - | HCV | - | HTLV-1 | - | ||
| EBV | - | HBV | - | HIV-1 | - | HTLV-2 | - | ||
| HHV6 | - | HTLV-1 | - | HIV-2 | - | HAV | - | ||
| HHV7 | - | HTLV-2 | - |
-/negative. +/positive. nt/not tested. (positive (+) does not immediately mean the production of infectious viral particles.) |
|||||
| BKV | - | HIV-1 | - | ||||||
| JCV | - | HIV-2 | - | ||||||
| ADV | - | HPV18 | - | ||||||
| Notes | |||||||||
| Images |
|---|
![]() ![]() ![]() ![]() ![]() ![]() ![]() ![]() ![]() ![]() |
| Movies |
|---|
|
|
LOT Information
生細胞率、増殖速度、細胞濃度はバンクでのロット作製時の実測値として記していますが、保証値ではございません。また、倍加時間は継代間で計測したラフな値です。Viability/Growth rate/Cell number are represented as actual values measured at lot presentation in JCRB, but are not guaranteed values. Additionally, the doubling time is a rough value measured during passages.
| 細胞番号 | JCRB0813 | 細胞名 | |
|---|---|---|---|
| 培養ロット番号 | 10052009 | 培養種別 | distribution |
| 培地 | Eagle's minimum essential medium with 10% fetal bovine serum (GIBCO Cat. # 10099) | 培養温度 | 37 C |
| 継代時細胞数(濃度) | approx. 6 - 7 x 10^4 cells/ml | 継代方法 | 0.25% trypsin and 0.02% EDTA |
| 増殖速度 | approx. 27 hrs | 凍結時生細胞濃度 | 8.6 x 10^5 |
| 凍結時生細胞率 | 97.7 | 使用抗生物質 | free |
| 継代数 | P29 | PDL数(プライマリ) | |
| マイコプラズマ検出 | - | 細菌汚染検出 | - |
| 真菌汚染検出 | - | アイソザイム検査・動物名 | Confirmed as human by NP, G6PD (type B), MD. |
| 染色体モード | 染色体情報 | ||
| 表面抗原 | DNA Profile (STR) | ||
| 接着性 | Yes | 導入外部遺伝子 | |
| 凍結培地 | 10% DMSO, 20% FBS - EMEM | 炭酸ガス濃度 | 5% |
| 解凍後生細胞率 | 追加情報 |
| 細胞番号 | JCRB0813 | 細胞名 | |
|---|---|---|---|
| 培養ロット番号 | 090595 | 培養種別 | distribution |
| 培地 | MEM +10%FCS | 培養温度 | 37 |
| 継代時細胞数(濃度) | 継代方法 | 0.25% trypsin and dilute in fresh medium. Change medium twice a week. | |
| 増殖速度 | 凍結時生細胞濃度 | ca3-5x10^6 | |
| 凍結時生細胞率 | 使用抗生物質 | penicillin/streptomycin | |
| 継代数 | P23 | PDL数(プライマリ) | |
| マイコプラズマ検出 | 細菌汚染検出 | ||
| 真菌汚染検出 | アイソザイム検査・動物名 | confirmed as human | |
| 染色体モード | 染色体情報 | ||
| 表面抗原 | DNA Profile (STR) | ||
| 接着性 | 導入外部遺伝子 | ||
| 凍結培地 | 炭酸ガス濃度 | ||
| 解凍後生細胞率 | 追加情報 |
| 細胞番号 | JCRB0813 | 細胞名 | |
|---|---|---|---|
| 培養ロット番号 | 102398 | 培養種別 | distribution |
| 培地 | Eagle's minimal essential medium with 10% fetal calf serum (FCS lot; BioWhittaker 6M0121) | 培養温度 | 37 C |
| 継代時細胞数(濃度) | 10^5 cells/ml | 継代方法 | 0.25% trypsin and 0.02% EDTA |
| 増殖速度 | D.T.=ca. 60 hrs | 凍結時生細胞濃度 | 2.4 x 10^6 |
| 凍結時生細胞率 | 91.0 | 使用抗生物質 | free |
| 継代数 | P29 | PDL数(プライマリ) | |
| マイコプラズマ検出 | - | 細菌汚染検出 | - |
| 真菌汚染検出 | - | アイソザイム検査・動物名 | Confirmed as human by NP, G6PD (type A), LD. |
| 染色体モード | 染色体情報 | ||
| 表面抗原 | DNA Profile (STR) | ||
| 接着性 | 導入外部遺伝子 | ||
| 凍結培地 | 炭酸ガス濃度 | ||
| 解凍後生細胞率 | 追加情報 |
| 細胞番号 | JCRB0813 | 細胞名 | VMRC-RCW |
|---|---|---|---|
| 培養ロット番号 | 11082016 | 培養種別 | distribution |
| 培地 | Eagle's minimum essential medium with 10% fetal bovine serum (FBS; Sigma Cat. # 172012) | 培養温度 | 37 C |
| 継代時細胞数(濃度) | 2.8 - 6.0 x 10^4 cells/mL | 継代方法 | Cells were harvested after treatment with 0.25% trypsin and 0.02% EDTA. |
| 増殖速度 | approx. 35 hrs. | 凍結時生細胞濃度 | 1.6 x 10^6 |
| 凍結時生細胞率 | 93 | 使用抗生物質 | free |
| 継代数 | P29 | PDL数(プライマリ) | |
| マイコプラズマ検出 | - | 細菌汚染検出 | - |
| 真菌汚染検出 | - | アイソザイム検査・動物名 | |
| 染色体モード | 染色体情報 | ||
| 表面抗原 | DNA Profile (STR) | ||
| 接着性 | Yes | 導入外部遺伝子 | |
| 凍結培地 | 10% DMSO, 20% FBS - EMEM | 炭酸ガス濃度 | 5% |
| 解凍後生細胞率 | 93 | 追加情報 |
| 細胞番号 | JCRB0813 | 細胞名 | VMRC-RCW |
|---|---|---|---|
| 培養ロット番号 | 07142023 | 培養種別 | distribution |
| 培地 | EMEM with 10% heat inactivated fetal bovine serum (SIGMA, Cat#172012, Lot#12J396) | 培養温度 | 37 C |
| 継代時細胞数(濃度) | 1.48-1.95x10^4 cells/sq.cm | 継代方法 | Cells were harvested after treatment with 0.25%trypsin(GIBCO) and 0.02% EDTA. |
| 増殖速度 | NT | 凍結時生細胞濃度 | 1.62x10^6 |
| 凍結時生細胞率 | 99 | 使用抗生物質 | free |
| 継代数 | p29 | PDL数(プライマリ) | NT |
| マイコプラズマ検出 | - | 細菌汚染検出 | - |
| 真菌汚染検出 | - | アイソザイム検査・動物名 | |
| 染色体モード | NT | 染色体情報 | NT |
| 表面抗原 | NT | DNA Profile (STR) | D5S818:12 D13S317:9 D7S820:8,10 D16S539:11,15 VWA:14,15 TH01:6,9.3 AM:Y TPOX:8 CSF1PO:11,12 |
| 接着性 | Yes | 導入外部遺伝子 | NT |
| 凍結培地 | BAMBANKER (LYMPHOTEC Inc., CS-02-001, NIPPON Genetics Co., LTD) | 炭酸ガス濃度 | 5% |
| 解凍後生細胞率 | 94 | 追加情報 |
| Images |
|---|
|
|